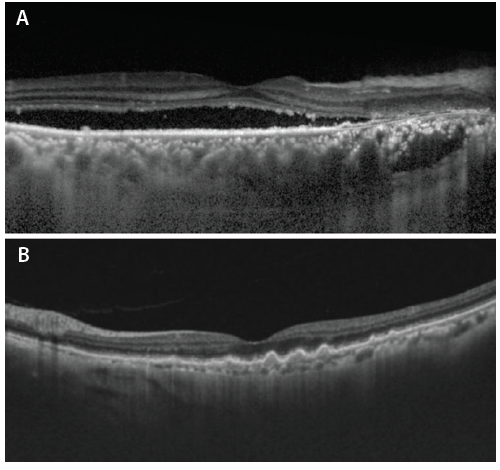

The advent of new imaging technologies including high-penetration OCT, OCT angiography (OCTA), and adaptive optics OCTA (AO-OCTA) has enabled better understanding and more detailed analysis of the choroidal layer.1,2 The information provided by these imaging modalities has made it possible for clinicians to describe multiple new disease entities.3-6 This article reviews these recent technological advancements and some of the disease entities that have recently been described thanks to these developments.
IMAGING THE CHOROID: LET US COUNT THE WAYS
When it comes to acquiring information about the choroid, the retina specialist has quite a few imaging options from which to choose.
OCT
OCT has many applications in retina, but the development by Spaide and others of enhanced-depth imaging OCT (EDI-OCT) a decade ago has allowed imaging of deeper retinal layers, including the choroid. EDI-OCT and swept-source OCT (SS-OCT) are particularly helpful if one is looking for evidence of a large choroidal vessel (Haller layer), medium choroidal vessel (Sattler layer), and/or a layer of choriocapillaries with clear distinction of the choroid’s outer and inner boundaries.1,2
Figure 1. SS-OCT scans showing variation of choroidal thickness in chorioretinal diseases. A thickened choroid is shown in a patient with CSCR (A), and choroidal thinning in a patient with AMD (B).
Choroidal Thickness
Choroidal thickness varies among disease states, and the choroid becomes thinner with increasing age and axial length.7 Choroidal thickness is increased in central serous chorioretinopathy (CSCR), polypoidal choroidal vasculopathy (PCV), and Vogt-Koyanagi-Harada syndrome but is decreased in age-related macular degeneration (AMD) (Figure 1).8-10 Choroidal thickness decreases from the macular area to the periphery and is at its maximum subfoveally and in the superior quadrant.11
Choroidal Volume
With closely spaced line scans and interpolation techniques, OCT can be used to estimate choroidal volume. These segmentation techniques have evolved from manual to automated, thereby increasing reproducibility and reducing scan times.12,13 Choroidal volume tends to decrease as axial length increases and, as with choroidal thickness, to decrease with age.14
Choroidal Vascularity
Improved binarization techniques have led to better demarcation between dark (luminal) and bright (stromal or interstitial) areas of the choroid.15,16 The ratio of dark areas to total choroidal area is representative of the area occupied by choroidal vessels: This is termed choroidal vascularity index, and it has been studied in a normal population and in various disorders including CSCR, AMD, Vogt-Koyanagi-Harada syndrome, diabetic retinopathy (DR), and tubercular multifocal serpiginoid choroiditis.17-21

Figure 2. Automated choroidal segmentation (A and B) and binarization (C) of an SS-OCT B-scan of a normal eye.
Choroidal Segmentation and Vessel Layer Thickness
Automated choroidal segmentation and vessel layer thickness analysis provides information on specific choroidal layers in normal eyes and in various disease conditions. For instance, significant thinning of medium choroidal vessels has been noted in nonpathologic myopic eyes.22 Segmentation involves identification of the choroidal inner boundary just below the highly reflective retinal pigment epithelium (RPE) band and the choroidal outer boundary (Figures 2A and 2B). Choroidal outer boundary delineation is difficult because of the absence of any natural division between choroid and sclera.13 Automated segmentation techniques have better reproducibility and are less time-consuming than manual methods.23,24 Automated Haller and Sattler layer segmentation provides further details about large and medium choroidal vessels, respectively. It is accomplished by binarization of choroid into stromal and luminal components (Figure 2C), identification of choroidal vessels, and finally, delineation of the vessels into large and medium.24,25
En Face Choroidal Imaging
A coronal view of choroidal vessels, showing their size and distribution patterns, can be obtained with en face choroidal imaging.16 Multiple choroidal anomalies, such as polyps and branching vascular networks in PCV, focal or diffuse dilatation of choroidal vessels in CSCR, or reduced vessel density in AMD, can be identified using this modality.26-28 En face OCT scans can also be used to identify choroidal neovascularization (CNV), especially the occult type, and to monitor response to treatment based on changes in lesion size or vascularity.28
3D Reconstruction
3D reconstruction was difficult to accomplish initially because OCT line scans provide details in vertical fashion only at specified points, with no information about the intervening areas. Recreating 3D models requires the use of interpolation techniques to provide details about the missing data29 in order to produce additional information about CNV, drusen, and changes in choroidal vasculature in eyes with CSCR and/or PCV.30
Widefield Imaging
Widefield imaging enables us to study the perimacular and peripheral choroid at the same level of detail as the macular choroid.31-33 Widefield choroidal thickness, choroidal vascularity, and choroidal layer analysis can provide clinicians with details of the peripheral choroid in normal eyes and in eyes with pathologic lesions that are better than what was possible previously.31,32
OCTA
OCTA is a noninvasive test that can be helpful in identifying CNV and monitoring its progression or regression after treatment. Quiescent CNV lesions located below the RPE in eyes with AMD display no leakage on standard fluorescein angiography (FA) and no subretinal or intraretinal fluid on OCT.34,35 A small number of these eyes may develop exudation with time, necessitating treatment.36 Using en face OCTA, automated quantification of CNV can be accomplished with good reproducibility, comparable to that of manual delineation.37,38 Choroidal voids denoted on OCTA indicate areas of reduced blood flow in the choriocapillaris. These voids can be present in various degenerative chorioretinal disorders including high myopia, retinitis pigmentosa (RP), Stargardt disease, and DR (Figure 3).39-42

Figure 3. OCTA scans of nonproliferative DR (A) and proliferative DR (B). Choriocapillary voids are more prominent in the eye with proliferative DR.
Adaptive Optics OCTA
AO-OCTA provides a detailed view of the choriocapillaris simulating histologic sections, along with morphometric parameters including RPE-choriocapillaris depth separation and capillary density, diameter, and length per unit area.43
THE MORE YOU SEE, THE MORE YOU KNOW
Numerous new disease entities and clinical anomalies have been described thanks to the information obtained from the novel imaging techniques discussed above.

Figure 4. This SS-OCT B-scan passing through the vertical meridian of a patient with high myopia reveals the presence of a posterior staphyloma. Dome-shaped maculopathy with associated subretinal fluid and thin choroid can also be seen.
DSM and SIM
Dome-shaped maculopathy (DSM) and staphyloma-induced serous maculopathy (SIM) are distinct choroidal contour-related anomalies in which there is an inward bulge of choroid at the macula or the edge of a staphyloma.44-46 DSM is seen most commonly in patients with high myopia and tends to be associated with chronic subretinal fluid (SRF) that is not amenable to treatment with anti-VEGF therapy (Figure 4).44 SIM is similar in pathology to DSM but is seen at the borders of a staphyloma and may or may not be associated with SRF.46
Age-Related Choroidal Atrophy
Age-related choroidal atrophy is a term coined by Richard F. Spaide, MD, to describe eyes with significant choroidal thinning. Most of these eyes had only minimal retinal or RPE changes and therefore did not qualify as having AMD. However, the choroid was significantly thinner in these eyes, which is representative of changes related to aging.3

Figure 5. SS-OCT images of disease entities related to the pachychoroid spectrum: patient with PPE with disrupted ellipsoid zone and drusen-like deposit with no subretinal fluid (A); patient with CSCR, subretinal fluid, and elongated photoreceptors (B). SS-OCT scan of a patient with PNV with subretinal pigment epithelium neovascularization, subretinal fluid, and exudation (C).
Pachychoroid Spectrum
Disease entities with abnormally thickened choroid comprise the pachychoroid spectrum. These entities were described based on distinct clinical findings obtained through the use of EDI-OCT or SS-OCT imaging. They include pachychoroid pigment epitheliopathy (PPE), CSCR, pachychoroid neovasculopathy (PNV), and PCV (Figure 5).47 An interesting finding in these eyes is the presence of pachyvessels, which are characterized by a thickened Haller layer with compression of the Sattler layer and choriocapillaris.47
Focal Choroidal Excavation
Focal choroidal excavation (FCE) is an idiopathic excavation of the macular choroid without the presence of posterior staphyloma or ectasia.6 Conforming FCE forms when the photoreceptor layer remains apposed to the RPE and extends within the concavity of FCE without
any hyporeflective space. Nonconforming FCE forms when the photoreceptor layer detaches from the RPE with the formation of a hyporeflective space.48,49
Pachydrusen
Drusen are extracellular hyaline excrescences between the RPE and Bruch membrane. They can be hard or soft. Subretinal drusenoid deposits, as the name suggests, are located above the RPE.50 Pachydrusen is a recently described variant of drusen seen in eyes with AMD and PCV. These deposits are associated with thickened choroid and have a different morphology and topographic location compared with soft drusen.4,51

Figure 6. Rendered infrared image (A) and SS-OCT scan (B) of a patient with thickened choroid and multiple hyperreflective foci in the choroid. Subretinal fluid, double layer sign, and notched pigment epithelial detachment can also be observed.
Choroidal Hyperreflective Foci
Choroidal hyperreflective foci have been described in many chorioretinal pathologies, including Stargardt disease, RP, and CSCR (Figure 6).52-54 The mechanism that has been proposed for their formation is the loss of photoreceptors, with migration of RPE cells within the choroid. The number of hyperreflective foci tends to increase with disease severity.52
Choroidal Caverns
Choroidal caverns is an OCT finding that has been described in patients with geographic atrophy in AMD. These findings appear as hyporeflective cavities with hyperreflective borders involving either the Haller or Sattler layer and with preserved choriocapillaris.55
ICC
Intrachoroidal cavitation (ICC) was initially described as a hyporeflective space in the peripapillary choroid of patients with high myopia, usually at the inferior border of the myopic conus.5,56 It is important to differentiate these lesions from pseudoperipapillary ICC, which are hyporeflective areas that correspond with a large choroidal vessel on fundus photography.57 Temporal ICC is characterized by larger size and, unlike peripapillary ICC, may not be localized to the margins of the disc.58 Whether temporal ICC and choroidal cleft are similar pathologies based on their clinical OCT appearance and location is a matter for further research.
HERE’S LOOKING AT YOU, CHOROID
The new ophthalmic imaging modalities described above have provided clinicians with better tools for understanding chorioretinal pathologies. However, unfilled spaces and gaps still remain. These imaging techniques do not yet provide the fine detail seen in a true histologic section.
1. Spaide RF, Koizumi H, Pozonni MC. Enhanced depth imaging spectral-domain optical coherence tomography. Am J Ophthalmol. 2008;146(4):496-500.
2. Choma MA, Sarunic MV, Yang C, Izatt JA. Sensitivity advantage of swept source and Fourier domain optical coherence tomography. Opt Express. 2003;11(18):2183-2189.
3. Spaide RF. Age-related choroidal atrophy. Am J Ophthalmol. 2009;147(5):801-810.
4. Spaide RF. Disease expression in nonexudative age-related macular degeneration varies with choroidal thickness. Retina. 2018;38(4):708-716.
5. Spaide RF, Akiba M, Ohno-Matsui K. Evaluation of peripapillary intrachoroidal cavitation with swept source and enhanced depth imaging optical coherence tomography. Retina. 2012;32(6):1037-1044.
6. Margolis R, Mukkamala SK, Jampol LM, et al. The expanded spectrum of focal choroidal excavation. Arch Ophthalmol. 2011;129(10):1320-1325.
7. Tuncer I, Karahan E, Zengin MO, Atalay E, Polat N. Choroidal thickness in relation to sex, age, refractive error, and axial length in healthy Turkish subjects. Intl Ophthalmol. 2015;35(3):403-410.
8. Kuroda S, Ikuno Y, Yasuno Y, et al. Choroidal thickness in central serous chorioretinopathy. Retina. 2013;33(2):302-308.
9. Maruko I, Iida T, Sugano Y, et al. Subfoveal choroidal thickness after treatment of Vogt–Koyanagi–Harada disease. Retina. 2011;31(3):510-517.
10. Manjunath V, Goren J, Fujimoto JG, Duker JS. Analysis of choroidal thickness in age-related macular degeneration using spectral-domain optical coherence tomography. Am J Ophthalmol. 2011;152(4):663-668.
11. Hoseini-Yazdi SH, Vincent SJ, Collins MJ, Read SA, Alonso-Caneiro D. Wide-field choroidal thickness in myopes and emmetropes. Poster presented at: Association for Research in Vision and Ophthalmology Annual Meeting; May 7-11, 2017; Baltimore, MD.
12. Chhablani J, Barteselli G, Wang H, et al. Repeatability and reproducibility of manual choroidal volume measurements using enhanced depth imaging optical coherence tomography. Invest Ophthalmol Vis Sci. 2012;53(4):2274-2280.
13. Kajić V, Esmaeelpour M, Považay B, et al. Automated choroidal segmentation of 1060 nm OCT in healthy and pathologic eyes using a statistical model. Biomed Opt Express. 2012;3(1):86-103.
14. Barteselli G, Chhablani J, El-Emam S, et al. Choroidal volume variations with age, axial length, and sex in healthy subjects: a three-dimensional analysis. Ophthalmology. 2012;119(12):2572-2578.
15. Sonoda S, Sakamoto T, Yamashita T, et al. Luminal and stromal areas of choroid determined by binarization method of optical coherence tomographic images. Am J Ophthalmol. 2015;159(6):1123-1131.e1121.
16. Vupparaboina KK, Richhariya A, Chhablani J, Jana S. Optical coherence tomography imaging: Automated binarization of choroid for stromal-luminal analysis. Paper presented at: International Conference on Signal and Information Processing; October 6-8, 2016; Nanded, India.
17. Agrawal R, Gupta P, Tan K-A, et al. Choroidal vascularity index as a measure of vascular status of the choroid: Measurements in healthy eyes from a population-based study. Sci Rep. 2016;6:21090.
18. Agarwal A, Agrawal R, Khandelwal N, et al. Choroidal structural changes in tubercular multifocal serpiginoid choroiditis. Ocul Immunol Inflamm. 2018;26(6):838-844.
19. Agrawal R, Chhablani J, Tan K-A, et al. Choroidal vascularity index in central serous chorioretinopathy. Retina. 2016;36(9):1646-1651.
20. Agrawal R, Li LKH, Nakhate V, Khandelwal N, Mahendradas P. Choroidal vascularity index in Vogt-Koyanagi-Harada disease: an EDI-OCT derived tool for monitoring disease progression. Transl Vis Sci Technol. 2016;5(4):7.
21. Tan KA, Laude A, Yip V, et al. Choroidal vascularity index–a novel optical coherence tomography parameter for disease monitoring in diabetes mellitus? Arch Ophthalmol. 2016;94(7):e612-e616.
22. Alshareef RA, Khuthaila MK, Januwada M, et al. Choroidal vascular analysis in myopic eyes: evidence of foveal medium vessel layer thinning. Int J Retina Vitreous. 2017;3(1):28.
23. Zhang L, Buitendijk GH, Lee K, et al. Validity of automated choroidal segmentation in SS-OCT and SD-OCT. Invest Ophthalmol Vis Sci. 2015;56(5):3202-3211.
24. Uppugunduri SR, Rasheed MA, Richhariya A, et al. Automated quantification of Haller’s layer in choroid using swept-source optical coherence tomography. PLoS One. 2018;13(3):e0193324.
25. Esmaeelpour M, Kajic V, Zabihian B, et al. Choroidal Haller’s and Sattler’s layer thickness measurement using 3-dimensional 1060-nm optical coherence tomography. PLoS One. 2014;9(6):e99690.
26. Alasil T, Ferrara D, Adhi M, et al. En face imaging of the choroid in polypoidal choroidal vasculopathy using swept-source optical coherence tomography. Am J Ophthalmol. 2015;159(4):634-643.e632.
27. Ferrara D, Mohler KJ, Waheed N, et al. En face enhanced-depth swept-source optical coherence tomography features of chronic central serous chorioretinopathy. Ophthalmology. 2014;121(3):719-726.
28. Lau T, Wong IY, Iu L, et al. En-face optical coherence tomography in the diagnosis and management of age-related macular degeneration and polypoidal choroidal vasculopathy. Indian J Ophthalmol. 2015;63(5):378.
29. Srinath N, Patil A, Kumar VK, et al. Automated detection of choroid boundary and vessels in optical coherence tomography images. Paper presented at: 36th Annual International Conference of the IEEE Engineering in Medicine and Biology Society; August 26-30, 2014; Chicago, IL.
30. St Clair RM, Orlin A, Aaker GD, et al. Three-dimensional volumetric ‘cast’of the choroid using enhanced depth imaging optical coherence tomography. Invest Ophthalmol Vis Sci. 2011;52(14):4034-4034.
31. McNabb RP, Grewal DS, Mehta R, et al. Wide field of view swept-source optical coherence tomography for peripheral retinal disease. Br J Ophthalmol. 2016;100(10):1377-1382.
32. Singh SR, Invernizzi A, Rasheed MA, et al. Wide-field choroidal vascularity in healthy eyes. Am J Ophthalmol. 2018;193:100-105.
33. Kolb JP, Klein T, Kufner CL, et al. Ultra-widefield retinal MHz-OCT imaging with up to 100 degrees viewing angle. Biomed Opt Express. 2015;6(5):1534-1552.
34. Querques G, Srour M, Massamba N, et al. Functional characterization and multimodal imaging of treatment-naive “quiescent” choroidal neovascularization. Invest Ophthalmol Vis Sci. 2013;54(10):6886-6892.
35. Palejwala NV, Jia Y, Gao SS, et al. Detection of non-exudative choroidal neovascularization in age-related macular degeneration with optical coherence tomography angiography. Retina. 2015;35(11):2204.
36. Capuano V, Miere A, Querques L, et al. Treatment-naive quiescent choroidal neovascularization in geographic atrophy secondary to nonexudative age-related macular degeneration. Am J Ophthalmol. 2017;182:45-55.
37. Gao SS, Liu L, Bailey ST, et al. Quantification of choroidal neovascularization vessel length using optical coherence tomography angiography. J Biomed Opt. 2016;21(7):076010.
38. Zhang Q, Chen C-L, Chu Z, et al. Automated quantitation of choroidal neovascularization: a comparison study between spectral-domain and swept-source OCT angiograms. Invest Ophthalmol Vis Sci. 2017;58(3):1506-1513.
39. Al-Sheikh M, Phasukkijwatana N, Dolz-Marco R, et al. Quantitative OCT angiography of the retinal microvasculature and the choriocapillaris in myopic eyes. Invest Ophthalmol Vis Sci. 2017;58(4):2063-2069.
40. Spaide RF. Choriocapillaris flow features follow a power law distribution: implications for characterization and mechanisms of disease progression. Am J Ophthalmol. 2016;170:58-67.
41. Dodo Y, Suzuma K, Ishihara K, et al. Clinical relevance of reduced decorrelation signals in the diabetic inner choroid on optical coherence tomography angiography. Sci Rep. 2017;7(1):5227.
42. Coscas G, Lupidi M, Coscas F, Chhablani J, Cagini C. Optical coherence tomography angiography in healthy subjects and diabetic patients. Ophthalmologica. 2018;239(2-3):61-73.
43. Kurokawa K, Liu Z, Miller DT. Adaptive optics optical coherence tomography angiography for morphometric analysis of choriocapillaris. Biomed Opt Express. 2017;8(3):1803-1822.
44. Lorenzo D, Arias L, Choudhry N, et al. Dome-shaped macula in myopic eyes: twelve-month follow-up. Retina. 2017;37(4):680-686.
45. Gaucher D, Erginay A, Lecleire-Collet A, et al. Dome-shaped macula in eyes with myopic posterior staphyloma. Am J Ophthalmol. 2008;145(5):909-914.
46. Yzer S, Martinez JP, Mrejen S, Boon CJ, Gallego-Pinazo R. Staphyloma-induced serous maculopathy. Invest Ophthalmol Vis Sci. 2015;56(7):3852-3852.
47. Gallego-Pinazo R, Dolz-Marco R, Gómez-Ulla F, Mrejen S, Freund KB. Pachychoroid diseases of the macula. Med Hypothesis Discov Innov Ophthalmol. 2014;3(4):111.
48. Kuroda Y, Tsujikawa A, Ooto S, et al. Association of focal choroidal excavation with age-related macular degeneration. Invest Ophthalmol Vis Sci. 2014;55(9):6046-6054.
49. Chung H, Byeon SH, Freund KB. Focal choroidal excavation and its association with pachychoroid spectrum disorders. Retina. 2017;37(2):199-221.
50. Zweifel SA, Spaide RF, Curcio CA, Malek G, Imamura Y. Reticular pseudodrusen are subretinal drusenoid deposits. Ophthalmology. 2010;117(2):303-312.e301.
51. Lee J, Byeon SH. Prevalence and clinical characteristics of pachydrusen in polypoidal choroidal vasculopathy: Multimodal Image Study [published online ahead of print January 16, 2018]. Retina.
52. Piri N, Nesmith BL, Schaal S. Choroidal hyperreflective foci in Stargardt disease shown by spectral-domain optical coherence tomography imaging: correlation with disease severity. JAMA Ophthalmol. 2015;133(4):398-405.
53. Kawaguchi Y, Takahashi A, Nagaoka T, et al. Retinal and choroidal hyperreflective foci on spectral-domain optical coherence tomographic images in a patient with retinitis pigmentosa accompanied by diabetic retinopathy. Am J Ophthalmol Case Rep. 2016;3:25-30.
54. Daruich A, Matet A, Dirani A, et al. Central serous chorioretinopathy: recent findings and new physiopathology hypothesis. Prog Retin Eye Res. 2015;48:82-118.
55. Querques G, Costanzo E, Miere A, Capuano V, Souied EH. Choroidal caverns: a novel optical coherence tomography finding in geographic atrophy. Inv Ophthal Vis Sci. 2016;57(6):2578-2582.
56. Freund KB, Ciardella AP, Yannuzzi LA, et al. Peripapillary detachment in pathologic myopia. Arch Ophthalmol. 2003;121(2):197-204.
57. You QS, Peng XY, Chen CX, Xu L, Jonas JB. Peripapillary intrachoroidal cavitations. The Beijing eye study. PLoS One. 2013;8(10):e78743.
58. Ohno-Matsui K, Shimada N, Akiba M, et al. Characteristics of intrachoroidal cavitation located temporal to optic disc in highly myopic eyes. Eye. 2013;27(5):630.
Jay Chhablani, MD
Vitreoretinal Consultant, Smt. Kanuri Santhamma Centre for Vitreoretinal Disease, L.V. Prasad Eye Institute, Hyderabad, India
jay.chhablani@gmail.com
Financial disclosure: None
Sumit Randhir Singh, MD
Vitreoretinal Specialist, Smt. Kanuri Santhamma Centre for Vitreoretinal Disease, L.V. Prasad Eye Institute, Hyderabad, India
Financial disclosure: None acknowledged
Sushma J, MBBS, DNB
Consultant Vitreoretinal Surgeon, Smt. Kanuri Santhamma Centre for Vitreoretinal Disease, L.V. Prasad Eye Institute, Hyderabad, India
Financial disclosure: None acknowledged


















